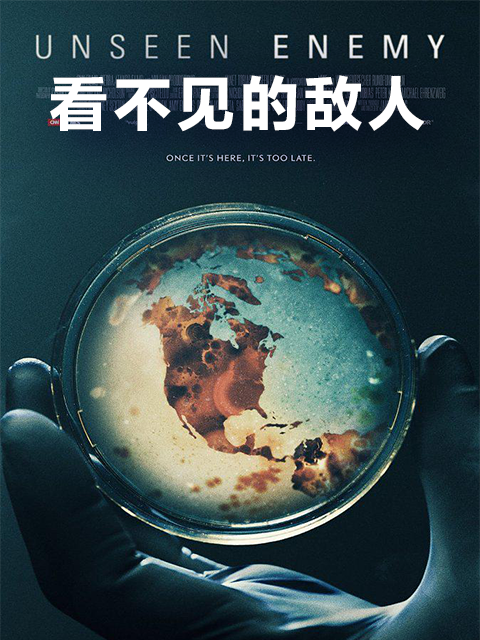

公告通知
山海官方资源全网首选:高清画质、热播影片、高峰不卡、官方同步更新!欢迎采集。
温馨提示:本站影片封面使用官方地址,如果部分图片不显示
【点此下载破解图片防盗链文件】
主域名:
gc.wki8.com
Telegram飞机交流群:
https://t.me/shanhaia
需要采集的站长登录
vip.wki8.com 自助购买授权
稳定高速官解切片:
https://json.xophp.com/
影片信息
剧情介绍
《看不见的敌人》是对21世纪人口正在经历一系列疾病的根本性探索,这些疾病曾经只是暴发,但现在已经成为全面的流行病。通过对埃博拉、流感和寨卡三种流行病的案例研究,向公众解释了我们面临的风险增加,以及社会和个人共同努力降低风险的方式。在全球各地,我们遇到了医生、疾病侦探和日常生活中的人们,他们已经步入了流行病的恐怖之中,并发生了深刻的变化。流行病带来了人类最好和最坏的行为,其影响远远超过疾病和死亡的代价。
播放类型:bilibili
无需下载任何插件
为了防止爬虫,播放地址不再显示,如有需要请登录vip.wki8.com购买授权采集


